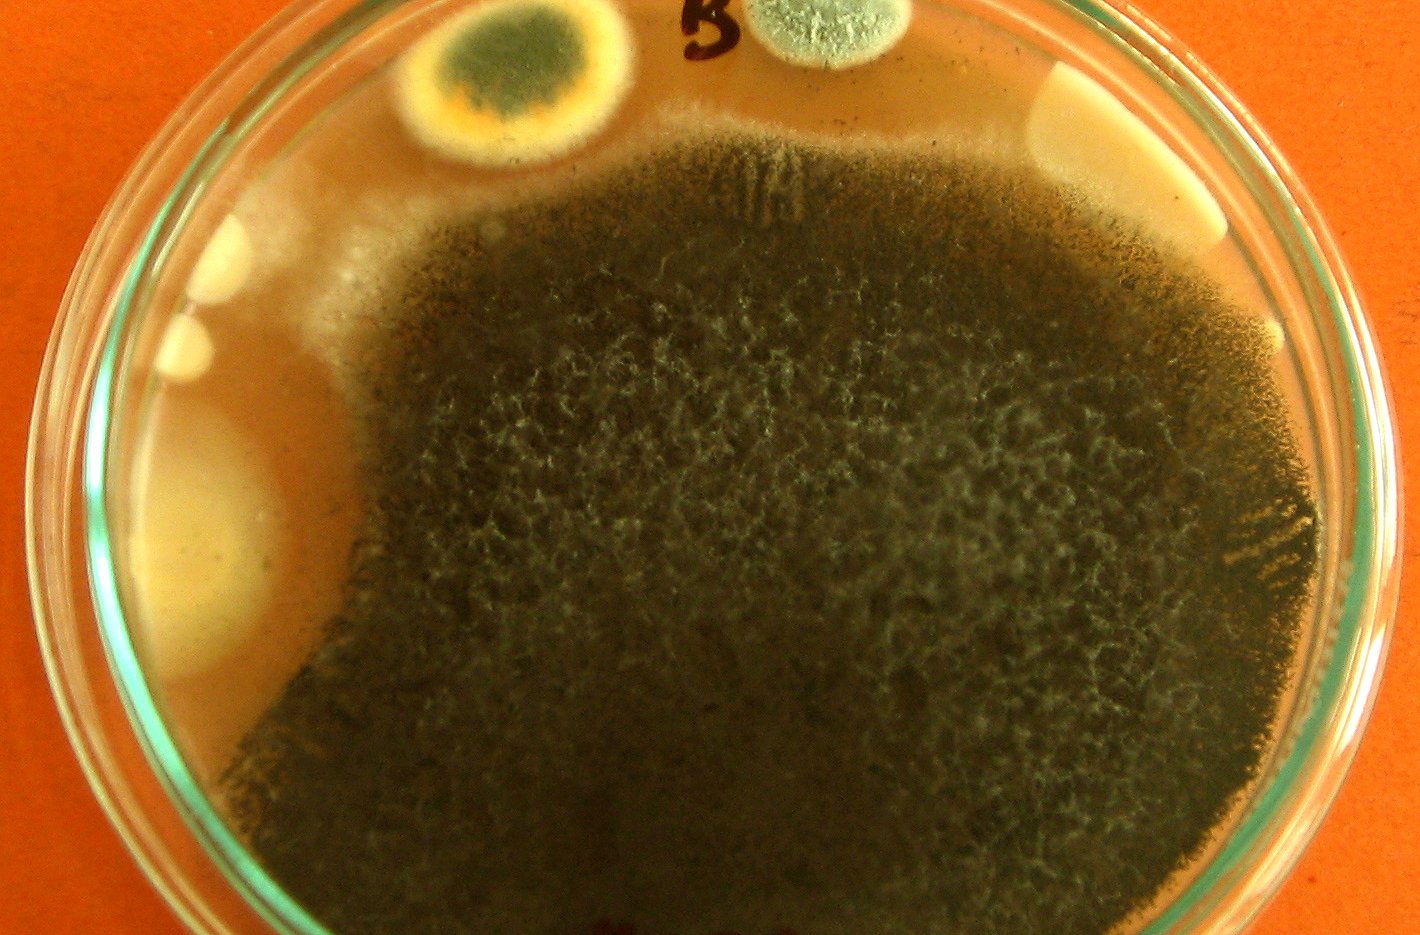

Mikotoksyny to wytarzane przez grzyby strzępkowe (często nazywane pleśniami) substancje, które znajdujemy m.in. w produktach spożywczych i paszach (w tym w ziarnie kukurydzy, kiszonkach, śrucie zbożowej i sojowej).
Niektóre mikotoksyny mogą być przenoszone z mlekiem matki, znajdowane są także w produktach mlecznych i innych produktach pochodzenia zwierzęcego. Mikotoksyny produkowane są m.in. przez grzyby z rodzajów Aspergillus i Penicillium (aflatoksyny, ochratoksyny, patulina) oraz Fusarium (deoksyniwalenol, zearalenon, moniliformina, T-2, HT-2, fumonizyny).
Zwalczanie grzybów produkujących mikotoksyny opisano we wcześniejszych tekstach zamieszczonych w tym serwisie, np.: „Fuzarioza groźna dla kukurydzy” czy „Mikotoksyny zagrożeniem dla zdrowia”. Poniżej przedstawiamy, dlaczego mikotoksyny są groźne.
Najogólniej można powiedzieć, że mikotoksyny to substancje pochodzenia grzybowego, które oddziałują szkodliwie na organizmy zwierząt i człowieka. Mikotoksyny wnikają do tych organizmów za pośrednictwem układu pokarmowego i oddechowego, kontakt następuje także przez skórę.
Choroby wywoływane przez mikotoksyny to tzw. mikotoksykozy. Toksyny mogą wywoływać zatrucia ostre i przewlekłe. Szkodliwy wpływ mikotoksyn obejmuje m.in.:
Skutki działania toksyn zależą od gatunku zwierząt, ich wieku i diety, a także od rodzaju, dawki i czasu oddziaływania szkodliwych substancji. W skrajnych przypadkach wynikiem działania mikotoksyn może być śmierć organizmu.
[1] Selwet M. 2010. Negatywne aspekty występowania wybranych mikotoksyn w paszach. Wiadomości Zootechniczne, XLVIII, 1, 9-13.
[2] Wróbel B. 2014. Zagrożenia zwierząt i ludzi toksynami grzybów pleśniowych zawartych w paszach i żywności. Woda-Środowisko-Obszary Wiejskie, 14, 3(47), 159-176.
